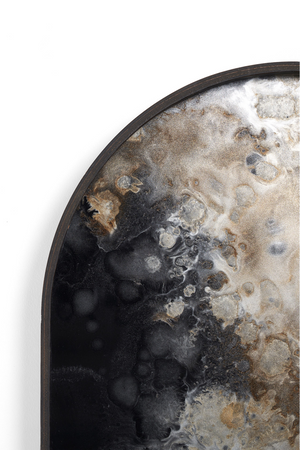
Oblong Glass Tray | Ethnicraft Black Organic | Oroa.com

Oblong Glass Tray | Ethnicraft Black Organic
Oblong Glass Tray | Ethnicraft Black Organic is backordered and will ship as soon as it is back in stock.
Working on an interior design project? Looking for quantities or personalization for hospitality?
Our Senior Consultants will help you.
Description
Description
The Oblong Glass Tray flaunts subdued color palette meets captivating motifs inspired by nature and travel. This Ethnicraft Black Organic glass valet tray explores the interplay of intricate patterns against muted tones, revealing the beauty behind the deceivingly ordinary subjects from which inspiration is drawn. Through this artistic endeavor, it captures the essence of timelessness.
- W28 x D15 x H2 in | Weight 7lbs
- W71 x D38 x H5 cm | Weight 3kgs
- Materials | Glass, Wood
- 2-year warranty & exclusive Belgium design
Specifications
Specifications
-
Material & Finish
-
Width
-
Depth
-
Height
-
Weight
-
Specification Sheet